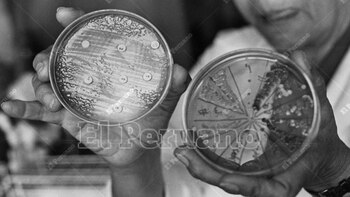
(El Peruano)

En tiempos en los que parece que dengue ha regresado al Perú y está causando estragos, sobre todo en la población de costa norte, no está de más recordar que en nuestro país ya sabemos de este tipo de situaciones y enfermedades.
Y no hablamos del COVID-19, que todavía provoca algunos contagios en estos días.
Nos referimos a la presencia del cólera, una pandemia que castigó al Perú por casi una década y causó la muerte de casi tres mil personas. Una situación que se pudo evitar de haber tenido la información correcta. Esto es la historia de lo que realmente pasó en el Perú en 1991.
Síntomas

Era el verano del inicio de la última década del siglo XX, cuando el bacilo del Vibrio cholerae hizo su aparición en este país.
Al principio, olas de enfermos llegaban a postas y hospitales con los mismos síntomas: dolores musculares, diarrea y vómitos.
Cuerpos literalmente secos, eran la prueba de la feroz deshidratación que atacaba desde un primer instante a las víctimas.
Exactamente, fueron 2909 víctimas mortales que dejó esta terrible enfermedad por tierras peruanas, convirtiéndose, además, en la epidemia más letal que pasó por el Perú desde la llegada de los españoles en el siglo XVI. Solo sería superada por el coronavirus
Su origen

Nacido en la India en el siglo XVI, el Vibrium Colérico sero grupo 01, Biotipo El Tor, serotipo Inaba (su nombre científico), no salió del gigante asiático por mucho tiempo.
Ni con las seis epidemias ocurridas entre 1817 y 1923. Hasta que llegó 1961 y una séptima comenzó, y llegó hasta 100 países. Hasta que le llegó al turno al Perú en enero de 1991. La presencia del Fenómeno El Niño ‘ayudó’ a su propagación por varios países de América Latina, sobre todos los más pobres.
Así llegó al Perú
Los primeros casos que reportó la prensa nacional de ese entonces se dieron en Chancay, Piura y Chimbote. Y desde ahí al resto del país en menos de dos meses.
De igual manera, se dio a conocer que la principal causa que las condiciones de extrema pobreza en la que vivían millones de peruanos, que incluían falta de acceso de agua potable y redes de alcantarillado.
A principios de la década de 1990, más de la mitad del país no tenía acceso a estos servicios básicos. En resumen, los pobres fueron los más perjudicados tan solo por su condición.

Aunque eso no era garantía que en las grandes ciudades, en donde sí había estos servicios, no pasara nada. Por ejemplo, en Piura y Trujillo, existían lugares en donde el agua se extraía en pozos. Algunos de estos ya estaban infectados a causa de los desagües.
En ese sentido, la Revista Peruana de Epidemiología publicó que en el Callao, el 40% del agua que era consumida tenía residuos fecales. En la Lima Metropolitana de 1991, la situación no era muy distinta. En muchos puntos la población se abastecía con agua de cisterna sin la más mínima supervisión sanitaria. Las aguas del desagüe era usada para regar cultivos de frutas y verduras. Nos jugábamos con la muerte.
Era fácil contagiarse
Lo anteriormente descrito no eras las únicas maneras que tenían los peruanos para contagiarse del cólera.
Hay que recordar que en esos años los problemas del Perú eran de toda índole. Al caso del terrorismo, habría que agregar que las vías de comunicación eran paupérrimas, no había suficientes postas médicas y era común ver grandes cantidades de basura en las principales calles de Lima, Calles y provincias.
El asunto era que ni sus ollas, ni los utensilios, ni los alimentos recibían la limpieza respectiva. Y sin el debido control sanitario, estos lugares también eran otro foco de infección para la trasmisión del cólera.
No había camas

Uno de los peores dramas que debe vivir un hospital es cuando no se da abasto para atender a una gran cantidad de pacientes. Ya lo vimos hace un par de años con la pandemia de Covid-19, a miles de pacientes que literalmente morían en la puerta de los centros de salud, porque no había cama para poder atenderlos. La misma desesperante situación se vivía en esos tiempos.
Cuentan crónicas de esos años que en determinado momento el hospital Cayetano Heredia llegó a atender a 200 pacientes por día. De igual manera, el hospital La Caleta (Chimbote) llegó a ver hasta 700 pacientes por día. Una locura.
En otras localidades, hasta se habilitaron colegios, parroquias y otros lugares que sirvieran como centros de salud, ya que los ‘oficiales’ no se daban abasto para tantos enfermos.
Así se le ganó al cólera

Luego de unos catastróficos primeros meses con el cólera en nuestro territorio, el Estado creó la Comisión Nacional Multisectorial de Lucha Contra el Cólera, que mediante persistentes campañas de difusión que promovían hábitos de limpieza elementales como lavarse las manos con agua y jabón; después de ir al baño, antes de comer, y de manera permanente.
Por último, también se hizo común el consumo de sales de rehidratación oral. Y aunque la tasa de mortalidad por cólera descendió hasta menos del 1%, la cifra se elevaba en las zonas más pobres del Perú.
Por ejemplo, en zonas rurales como en la selva subió al 6%; y en Cajamarca hasta el 10%. Finalmente, el Estado estimuló en la población que sus letrinas las construyan lejos de los ríos, para mantener el agua limpia.
Más Noticias
Magaly Medina tras ‘live’ de Pamela Franco y Melanie: “Es quitarle la careta a Christian Domínguez ante Karla”
En Magaly TV La Firme, la conductora aseguró que Karla Tarazona estaría en una ‘etapa de negació’ tras las declaraciones contra Christian Domínguez

Magaly Medina se burla de Christian Cueva escuchando a Pamela Franco hablar de su ex: “Se creyó todo el cuento”
La conductora no dudó en comentar como el futbolista esuchaba atento como su pareja hablaba de su ex Christian Domínguez

Karla Tarazona responde triste tras revelaciones de Pamela Franco sobre Christian Domínguez: “Hablaremos por interno”
Tras el polémico live de la cantante de cumbia, la exartista cómica aseguró que su relación con Christian Domínguez está ‘normal’ y que evitará responder públicamente para proteger a su familia

Magaly Medina tras revelación de Majo con Sabor: “Sus dos últimos ex han sido mediáticos”
Un comentario de Majo con Sabor durante un juego televisivo desató interpretaciones sobre su pasado sentimental, mientras Magaly Medina se preguntó a qué ex podría referirse

A qué hora juega Universitario vs UTC HOY: partido en el Monumental por Torneo Apertura de la Liga 1 2026
El elenco a cargo de Javier Rabanal apunta a volver a la victoria luego del duro tropiezo en Andahuaylas. Al frente, los de Carlos Bustos se presentan como un rival de cuidado. Conoce los horarios para este compromiso


